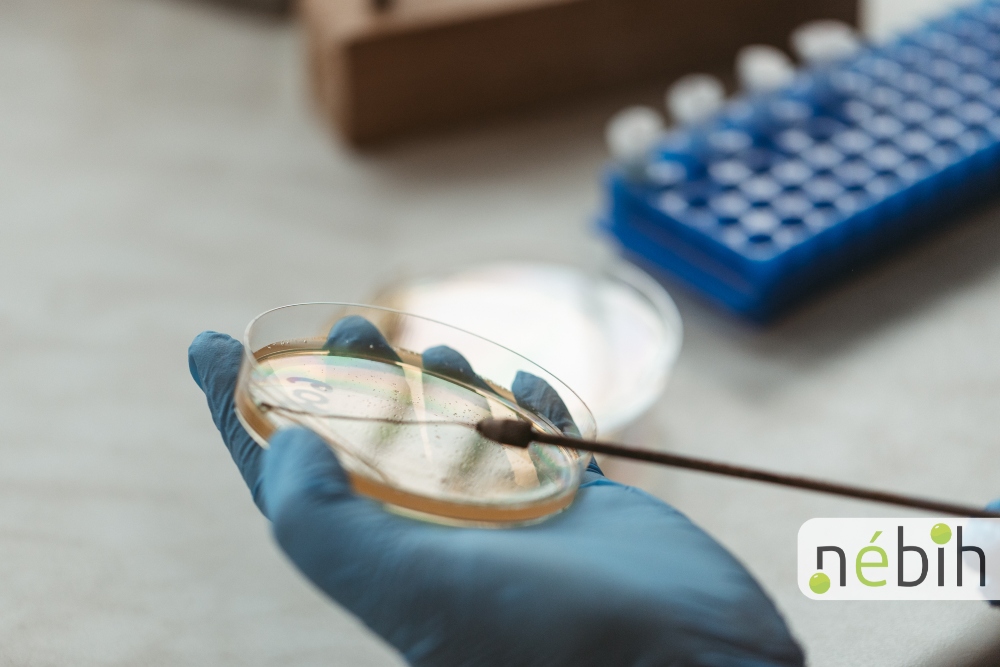
A fotón egy laborítóriumi szakember Petri csészében szélesztést végez.

A különböző grillezhető sajtok kétségkívül a kerti grillpartik nagy sztárjai, azonban a nyár elmúltával sem kell lemondanunk róluk! Őszi tesztünk keretében a mi tányérunkra is felkerültek: összesen 33 hazai előállítású grillsajtot és kiegészítésként kilenc kistermelői terméket vizsgáltunk meg, és bizony izgalmas eredmények születtek. Lássuk a részleteket!
Kívül ropogós, belül krémes és nyúlós… Nem véletlen, hogy sokak kedvencei a különböző grillezhető sajtok. Igazán ízletes saláták és főételek készíthetőek belőle, melyeket a nyár elmúltával sem kell elfelejtenünk, hiszen szezonális zöldségekkel, gyümölcsökkel kombinálva konyhai körülmények között, grillsütőlapon vagy serpenyőben egyaránt megsüthető. Éppen ezért már nem csak nyáron vásárolhatunk grillsajtot. Két különböző alkalommal (téli és nyári időszakban) is felmértük a hazai natúr és füstölt termékek kínálatát, ez alapján elmondható, hogy szinte azonos mértékű a választék, nincs jelentős bővülés a nyári időszakban.
Új utakon
Akik jól ismerik, régóta követik a Szupermenta tesztjeit, tudhatják, hogy rendszerint olyan termékek szerepelnek az összehasonlító vizsgálatokban, melyek elérhetőek a széles vásárlói közönség számára. Ezúttal azonban nemcsak a kereskedelmi láncokban kapható, hanem kistermelők által előállított termékek is bekerültek a tesztbe kiegészítésként.
Grillsajt-variációk
A kínálat felmérését követően összesen 33 grillsajt került a kosarunkba, melyek mindegyike Magyarországon készült. A 24 üzemi grillsajt között 16 natúr és 8 füstölt szerepelt, a 9 kistermelői sajt közül 6 natúr, 3 pedig füstölt volt. Kiszerelésüket tekintve leginkább 150-250 gramm között mozogtak, de több esetben találkoztunk egyedi mérlegelésű termékkel.
Tudta?
A grillsajt gyűjtőfogalom, amely különféle technológiai háttérrel készült sajtokat és sajtkészítményeket foglal magába. A Magyar Élelmiszerkönyv nem definiálja ezt a megnevezést, ezért a piacon nagy eltérések lehetnek a termékek között.
Mit takar a „grillsajt”?
A „grillsajtok” a tejtermékekről szóló Magyar Élelmiszerkönyv különböző kategóriáiba sorolhatók be attól függően, hogy hogyan készülnek, milyen alapanyagokat tartalmaznak, és milyen technológiával dolgozták fel őket. A tesztelt termékek között típusukat tekintve oltós alvasztású, érlelt, savas és vegyes alvasztású sajt, valamint sajtkészítmény és ömlesztett sajt egyaránt szerepelt.
A grillsajt teszt eredményközlő videójának szöveges leirata (pdf)
Laboratóriumi vizsgálatok
- Mikrobiológiai vizsgálatok (E.coli, Listeria Monocytogenes, Koaguláz pozitív staphylococcus)
- Szárazanyag-tartalom
- Víztartalom a zsírmentes sajtanyagban
- Zsírtartalom
- Zsírtartalom szárazanyagra
- Laktóz
- Kálium-nitrát
- Nátrium-nitrit
- Szorbinsav
A termékteszten a Magyar Élelmiszerkönyvnek való megfelelés ellenőrzése volt az elsődleges szempont, melyre minden terméknél sor került. A Nébih laboratóriumában a hibásnak azonosított grillsajtok esetében a termékek jelölését is megvizsgálták a szakemberek.
A termékteszten a Magyar Élelmiszerkönyvnek való megfelelés ellenőrzése volt az elsődleges szempont, melyre minden terméknél sor került. A Nébih laboratóriumában a hibásnak azonosított grillsajtok esetében a termékek jelölését is megvizsgálták a szakemberek.
A felmerült – főként minőségi és jelölési – hibák miatt az érintett termékeknél teljes körű hatósági ellenőrzés történt. Bekértük a termék gyártmánylapját, valamint a legtöbb esetben az összetevőkre vonatkozó specifikációkat egyaránt. Továbbá minden olyan dokumentációra igényt tartottunk, amelyek releváns információkkal bírtak a termék megalapozott vizsgálatához. Ezek figyelembevételével és a vonatkozó jogszabályok alapján megvizsgáltuk, hogy a termékek megfelelnek-e a hatályos előírásoknak, különösen a vásárlók tájékoztatására vonatkozó jelölési előírásoknak.
Mikrobiológiai vizsgálatok
A laboratóriumi vizsgálat alapján egy grillsajtnál az E. coli technológiai higiéniai kritérium „nem megfelelőnek” minősült, amely a gyártási folyamatban és/vagy a felhasznált nyersanyagok higiénés minőségében fennálló problémát jelez. A mérési eredmények alapján a kimutatott mennyiség nem jelent élelmiszerbiztonsági kockázatot, azonban a kedveltségi vizsgálatból – és ezáltal a rangsorból – kizárásra került a termék.
Az érintett gyártónak a gyártási higiéniát és a nyersanyag-kiválasztást javítania kell.
Tudta?
A 2073/2005/EK uniós rendelet meghatározza az élelmiszerekre vonatkozó mikrobiológiai kritériumokat. A „technológiai higiéniai kritérium” olyan kritérium, amely a gyártástechnológia elfogadható működését jelzi; egy olyan indikatív szennyezettségi értéket határoz meg, amely felett helyesbítő intézkedések szükségesek a technológiai higiénia élelmiszerjogi megfelelőségének biztosításához és a fogyasztók egészségének megóvásához. Az E. coli jelenléte technológiai higiéniai mutatónak számít: ha az előírt határértéket meghaladja, az nem feltétlenül a késztermék közvetlen veszélyét jelzi, de arra utal, hogy a gyártás körülményei nem feleltek meg a higiéniai követelményeknek és helyesbítő intézkedések szükségesek.
Kemény vagy félkemény?
A laboratóriumban megmérték a szakemberek, hogy a zsírmentes sajtanyagban mennyi víz található, így ellenőrizték a termék állományjellemző kategóriáját.
Egy sajtnál a „kemény” állományjellemző hibásan került feltüntetésre, mivel a laboratóriumi vizsgálat megállapította, hogy a termék a zsírmentes sajtanyagban lévő víztartalma alapján a „félkemény” kategóriába esik.
Zsírtartalom
A laboratóriumi mérések alapján a szárazanyagra vonatkoztatott zsírtartalom két grillsajt esetében meghaladta a jelölésen feltüntetett minimumértékhez képest engedélyezett +5 százalékpontos eltérést.
Az érintett gyártóknak helyesbítő intézkedéseket kell tenniük.
Tudta?
A Magyar Élelmiszerkönyv előírása szerint a sajtok jelölésén kötelező feltüntetni a zsírfokozatot (pl. zsíros, félzsíros), amelyeknek laboratóriumi vizsgálatok alapján igazolhatónak kell lennie. Az oltós alvasztású, érlelt sajtok esetén kötelező feltüntetni az állományjellemző csoport nevét is (pl. kemény, félkemény stb.).
Mit rejt a csomagolás?
A termékek jelölésvizsgálata magában foglalta a tejtermékekre vonatkozó Magyar Élelmiszerkönyvben szereplő jelölési előírások teljesülésének, valamint az uniós jelölési rendeletben foglalt előírások betartásának ellenőrzését.
A kistermelői sajtok jelölésének ellenőrzése során a hatósági ellenőrök eltérést tapasztaltak az általános jelölési szabályok, a kistermelői rendelet és a Magyar Élelmiszerkönyv előírásaihoz képest. Leggyakoribb hibaokok között szerepelt a megnevezés, az összetevők hiányos vagy nem megfelelő feltüntetése, a zsírfokozat hiánya, a nettó tömeg megjelenítése, valamint a minőségmegőrzési idő jelölése sem pontosan a szabályok szerint történt.
A zsírfokozat, valamint egyes sajtoknál az állományjellemző csoportnév feltüntetésének hiánya miatt az elvégzett laboreredmények nem voltak értékelhetőek.
A jelölésvizsgálat részletes eredményeiért kattintson ide!
Az engedélyezett üzemekben előállított sajtok esetében a hatósági ellenőrzés eredményeként elmondható, hogy egy grillsajtnál a technológiai higiéniai kritérium nem volt megfelelő, három terméknél pedig minőségi hibát állapítottak meg a szakemberek, továbbá hét termék jelölése nem felelt meg az előírásoknak. A hatóság az érintett termékek gyártói ellen hatósági eljárást indított. A teszt kiegészítéseként vizsgált egyes kistermelői sajtok sem feleltek meg teljes mértékben a jelölési szabályoknak, ezért ezek előállítóit felszólították a szakemberek a hibák javítására.
Szupermenta-tipp
- A boltok polcain különböző grillsajtokkal találkozhatunk, ezért érdemes vásárláskor alaposan elolvasni a jelölésen feltüntetett információkat, hogy a számunkra legmegfelelőbb terméket válasszuk.
- A grillsajtok túlnyomó többsége hőkezelt tejből készül, tehát fogyasztásra alkalmasak már a csomagolás felbontása után is, élelmiszerbiztonsági szempontból nem szükséges őket teljesen átsütni. A grillezés célja elsősorban a melegítés és a külső pirult réteg kialakítása, tehát az élvezeti érték növelése, nem pedig a mikrobiológiai biztonság biztosítása.
Kíváncsi a grillsajtok kedveltségi vizsgálatának eredményeire? Kattintson!
Kapcsolódó tartalmaink
ÖSSZESÍTETT EREDMÉNYEK
A részletes eredményeket
bemutató táblázatot
itt letöltheti!
KEDVELTSÉGI VIZSGÁLAT
Itt megtudhatja, milyen
szempontok szerint pontozták
a termékeket.





